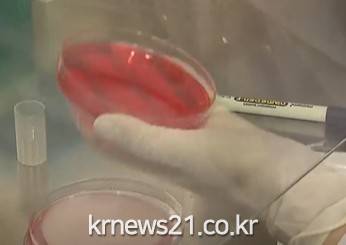

▲ 사진=KBS NEWS 영상 캡처
▲ 사진=KBS NEWS 영상 캡처진주의 한 어린이집에서 노로바이러스가 검출돼 보건당국이 역학조사에 나섰다.
진주시에 따르면 지난달 말 해당 어린이집 원생들이 복통 등을 호소하면서 조사가 시작돼, 최근 해당 어린이집에 보관 중이던 식품에서 노로바이러스가 확인됐다.
추가 조사 결과 원생 5명이 노로바이러스 양성 판정을 받았고, 진주시는 질병관리청에 조사을 의뢰했다.
 중문색달 해변
진모살 사빈 뒤편은 주상 절리의 해안 단애로 되어 있으며, 해수욕장과의 사이에는 20여m 높이의 사구층이 발달되어 있다. 바다에서 운반된 모래가 해안 단애에 막혀 사구층이 높게 형성되었다. 사구의 기저부에서 정상부까지는 30° 이상의 급사면을 이루어 강한 에너지에 의해 절벽 기저부까지 모래가 이동되고 있다. 해수욕장 동쪽 끝에 우...
중문색달 해변
진모살 사빈 뒤편은 주상 절리의 해안 단애로 되어 있으며, 해수욕장과의 사이에는 20여m 높이의 사구층이 발달되어 있다. 바다에서 운반된 모래가 해안 단애에 막혀 사구층이 높게 형성되었다. 사구의 기저부에서 정상부까지는 30° 이상의 급사면을 이루어 강한 에너지에 의해 절벽 기저부까지 모래가 이동되고 있다. 해수욕장 동쪽 끝에 우...
 120억 들여지은 경기 도서관
기록은 인간의 지식과 지혜, 정보를 후대에 전달해주기 위해 존재한다. 특히 권력자, 통치, 외교, 군사, 종교 등과 관련된 기록은 공적인 필요성에 의해 오랫동안 보존할 필요가 있었다. 그리고 각종 문서와 자료들을 오래 보전하기 위해 도서관이 생겨났다. 도서관을 단순히 책을 보관하는 장소로만 한정짓는다면, 그 기원은 문자의 사용 시.
120억 들여지은 경기 도서관
기록은 인간의 지식과 지혜, 정보를 후대에 전달해주기 위해 존재한다. 특히 권력자, 통치, 외교, 군사, 종교 등과 관련된 기록은 공적인 필요성에 의해 오랫동안 보존할 필요가 있었다. 그리고 각종 문서와 자료들을 오래 보전하기 위해 도서관이 생겨났다. 도서관을 단순히 책을 보관하는 장소로만 한정짓는다면, 그 기원은 문자의 사용 시.
 남해 다랭이 논
남해군 서남단 남면 홍현리 바닷가에 위치해 있다. 다랑이논은 농경시대 사람들의 전통적인 삶과 자연이 조화를 이룬 농업경관이다. 논은 설흘산과 응봉산 아래 바다를 향한 산비탈 급경사지에 조성되어 있다. 산의 지형을 따라 곡선 형태의 계단식 논이 100여 층 형성되어 있다.다랑이란 매우 규모가 작은 논을 지칭하는 단어이다. 특히 경..
남해 다랭이 논
남해군 서남단 남면 홍현리 바닷가에 위치해 있다. 다랑이논은 농경시대 사람들의 전통적인 삶과 자연이 조화를 이룬 농업경관이다. 논은 설흘산과 응봉산 아래 바다를 향한 산비탈 급경사지에 조성되어 있다. 산의 지형을 따라 곡선 형태의 계단식 논이 100여 층 형성되어 있다.다랑이란 매우 규모가 작은 논을 지칭하는 단어이다. 특히 경..
 익산시 천만송이 국화 축제
익산천만송이국화축제는 해마다 10월에 전라북도 익산시 어양동에 있는 중앙체육공원에서 개최되는 국화 축제이다. 불로장수와 강한 번식력을 자랑하는 국화는 전라북도 익산시의 시화로, 익산시의 무궁한 발전과 진취적인 기상을 상징한다. 익산천만송이국화축제는 익산시의 대표 축제 가운데 하나이다.
익산시 천만송이 국화 축제
익산천만송이국화축제는 해마다 10월에 전라북도 익산시 어양동에 있는 중앙체육공원에서 개최되는 국화 축제이다. 불로장수와 강한 번식력을 자랑하는 국화는 전라북도 익산시의 시화로, 익산시의 무궁한 발전과 진취적인 기상을 상징한다. 익산천만송이국화축제는 익산시의 대표 축제 가운데 하나이다.
 울산 석화 공단의 아침
[뉴스21일간=김태인 ]
울산 석화 공단의 아침
[뉴스21일간=김태인 ]

